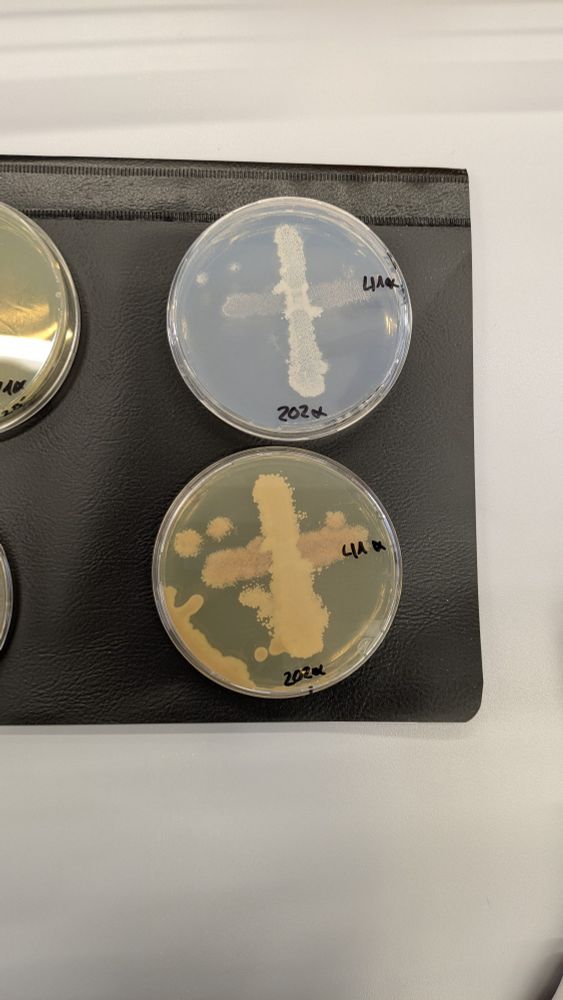

-
interests: motorsports, wintersports, books, music, writing, drawing, movies
-
currently working on a "let me introduce myself"-thread - could take a while though
-
biology student from germany :D




























for this break, have a picture of my favourite band - who they are will be solved later ;)

for this break, have a picture of my favourite band - who they are will be solved later ;)
your girl is going to see this dork like heheheheheeee

your girl is going to see this dork like heheheheheeee
(Yes the surroundings are pink. My led strip is in pink because it's a not so blue colour to sit in lol)

(Yes the surroundings are pink. My led strip is in pink because it's a not so blue colour to sit in lol)
Ich hab dich lieb, für immer, Opa 💔❤️🩹

Ich hab dich lieb, für immer, Opa 💔❤️🩹
33-prozent.com

![Text: 33% haben Hitler gereicht, um an die Macht zu kommen. Nur wenn wir wissen, wie es damals angefangen hat, können wir unsere Demokratie beschützen. Mehr auf [der Webseite] 33-prozent.com](https://cdn.bsky.app/img/feed_thumbnail/plain/did:plc:wtjr3cyppfcwx4xk3g4o2yv5/bafkreibfec3pwen3brnhjwj7sarp5zvoiroey2i3p4fuikqn3mypdv7ivy@jpeg)
33-prozent.com